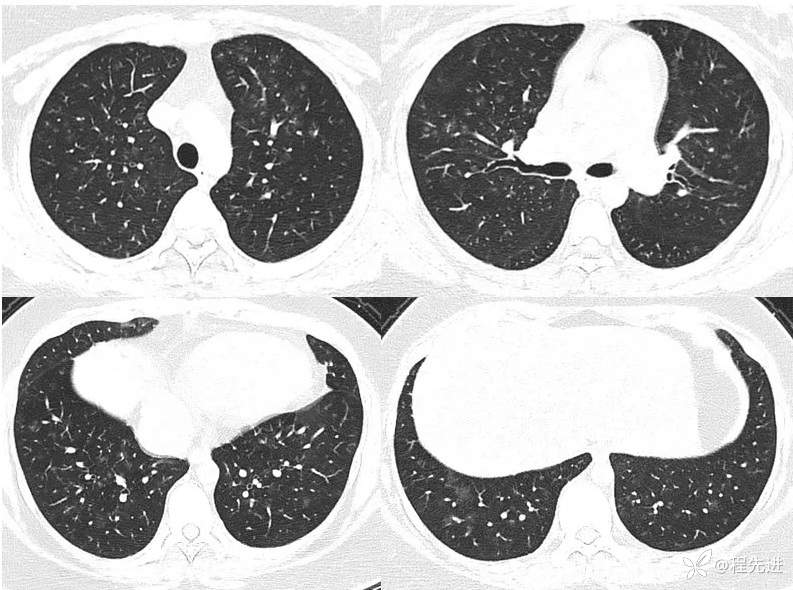
img
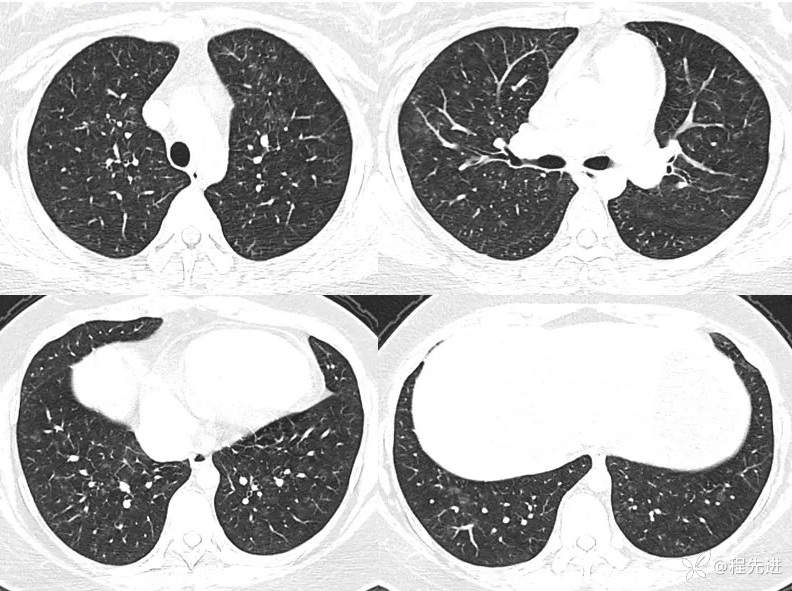
img

【心胸】特别精彩病例|咳嗽气促11个月
 呱呱叫了 等 3 位达人已点赞
呱呱叫了 等 3 位达人已点赞病例信息
患者性别:女
患者年龄:26岁
主诉:咳嗽气促11个月
现病史:患者11个月前无明显诱因下出现咳嗽,无痰,干咳为主,伴有胸闷、气促,活动后加重,无发热,畏寒及胸痛、咯血、晕等,曾在外院治疗,诊断为特发性肺动脉高压。
既往史:既往体健,无慢性病史
个人史:学生,无吸烟史、无有毒有害物品接触史
家族史:无特殊家族遗传病史
一月余前CT:



一月余后CT:



期待您的点赞支持!
期待您的精彩解读!
 呱呱叫了 等 3 位达人已点赞
呱呱叫了 等 3 位达人已点赞病例信息
患者性别:女
患者年龄:26岁
主诉:咳嗽气促11个月
现病史:患者11个月前无明显诱因下出现咳嗽,无痰,干咳为主,伴有胸闷、气促,活动后加重,无发热,畏寒及胸痛、咯血、晕等,曾在外院治疗,诊断为特发性肺动脉高压。
既往史:既往体健,无慢性病史
个人史:学生,无吸烟史、无有毒有害物品接触史
家族史:无特殊家族遗传病史
一月余前CT:

一月余后CT:

期待您的点赞支持!
期待您的精彩解读!
